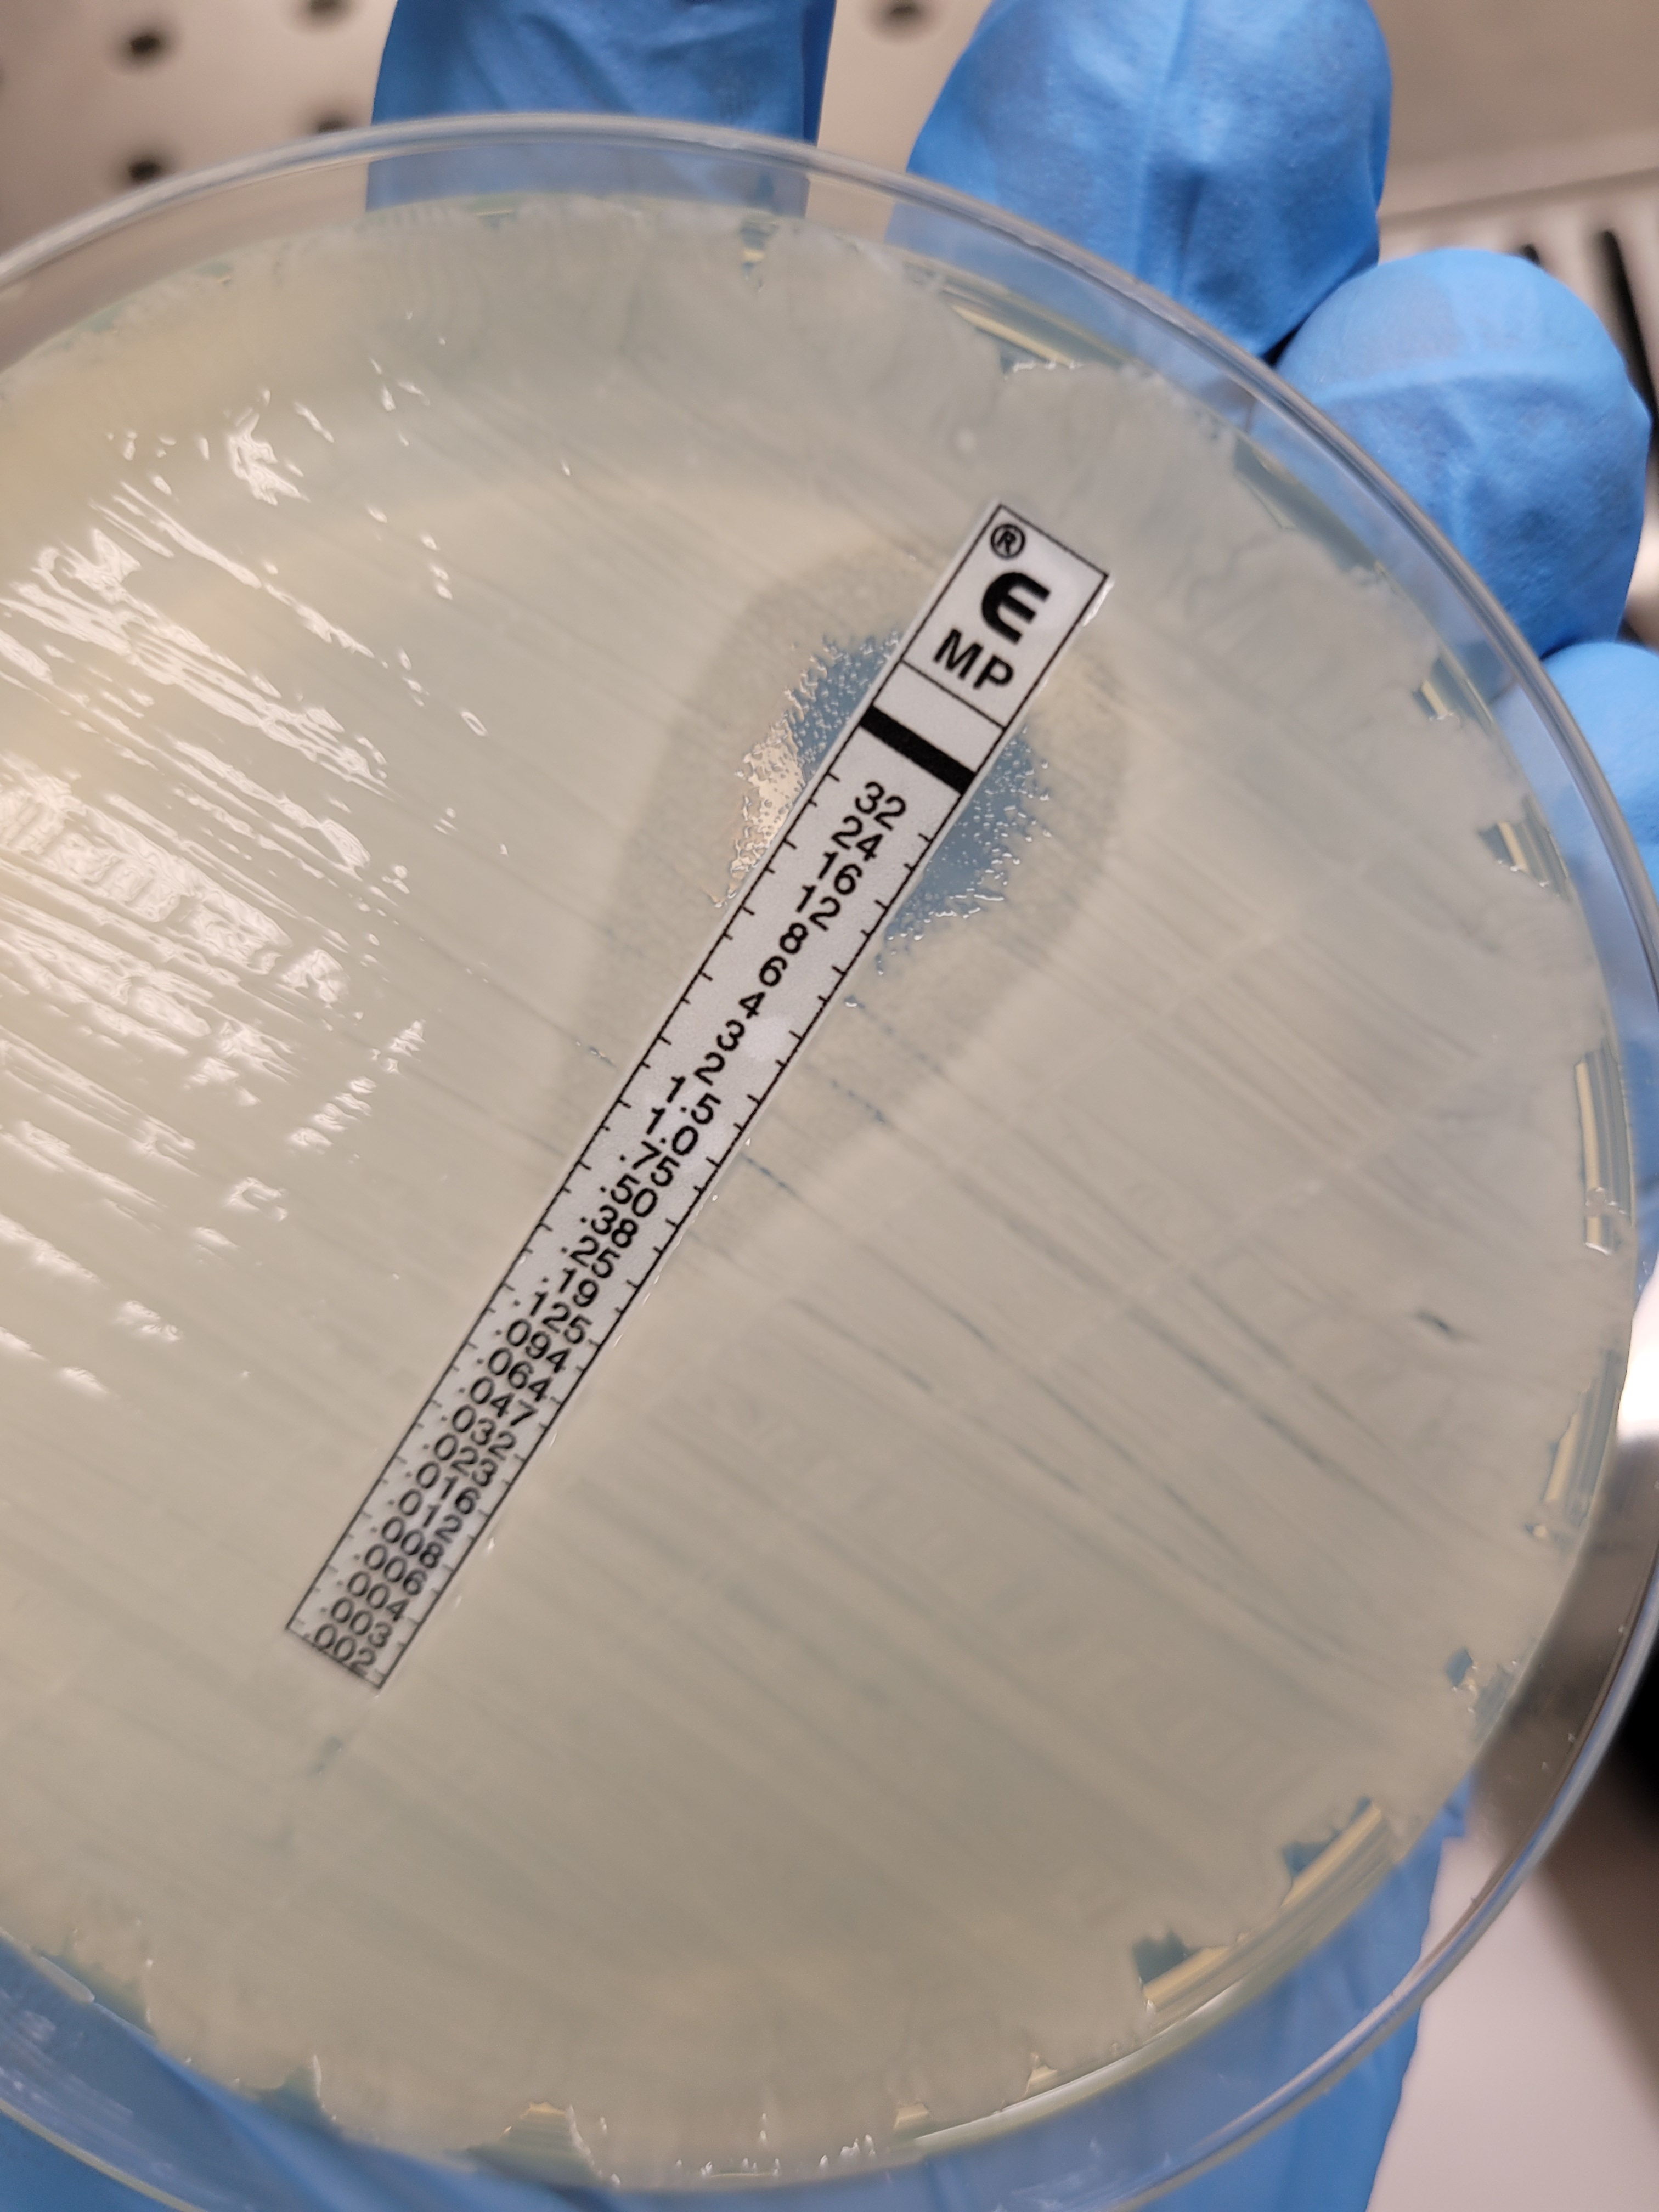

Principle Investigator: Irene Zaghi, M.D.
Supervisors:

“It was felt that there was a need of some definite basis for determining adequate therapy for each specific infectious organism involved…”
“Current methods in general use all depend on indirect comparisons (MICs, measurement of penicillin blood levels). In patients with more resistant organisms, it has not been demonstrated that this is the proper approach…”
“…It occurred to us that a more satisfactory method of outlining adequate therapy in resistant organisms might be based on the action of the patient’s own serum during penicillin administration.”



Prognostic performance similar or better than current susceptibility breakpoints
Concept: The assay will measure time taken for a standardized bacterial inoculum to “grow through” the antimicrobial activity in the patient’s serum under defined conditions.


R2 = 0.96-0.99


| Estimate | Lower .95 | Upper .95 | |
|---|---|---|---|
| 0.1 | 23.87874 | 19.31716 | 28.44033 |
| 0.25 | 26.93812 | 24.06902 | 29.80723 |
| 0.5 | 30.38948 | 29.11007 | 31.66888 |
| 0.75 | 34.28302 | 31.38838 | 37.17767 |
| 0.9 | 38.67541 | 33.84814 | 43.50268 |
| 0.95 | 41.98020 | 33.98412 | 49.97627 |
| Estimate | Lower .95 | Upper .95 | |
|---|---|---|---|
| 0.1 | 8.099087 | 7.038485 | 9.159689 |
| 0.25 | 9.235833 | 8.728989 | 9.742676 |
| 0.5 | 10.532127 | 10.149119 | 10.915134 |
| 0.75 | 12.010361 | 10.856802 | 13.163921 |
| 0.9 | 13.696074 | 11.685276 | 15.706872 |
| 0.95 | 14.975851 | 12.415855 | 17.535846 |
Figure 1: Pharmacodynamic relationship of Tpos to ceftazidime/avibactam concentrations
| Antibiotic combination | Strain (Ceftazidime-avibactam MIC mg/L) |
Mean Tpos change (hr) from predicted null response surface (95% CI) |
|---|---|---|
| CZA + GENT | KP_A; KPC (2) | +5.68 (5.09-6.53) |
| CZA + GENT | KP_B; KPC (1) | +3.05 (2.16-4.03) |
| CZA + GENT | KP_Catania; KPC (16) | +3.23 (2.10-4.14) |
| CZA + COL | KP_B; KPC (1) | +2.31 (1.40-3.20) |
| CZA + TGC | KP_B ;KPC (1) | +1.66 (0.72-2.73) |
| CZA + ATM | KP_NDM;NDM-2 (> 64) | +10.33 (10.32-10.34) |
| CZA + ATM | KP_Catania; KPC (16) | +10.36 (10.31-10.35) |
| CZA + MER | KP_B; KPC (1) | +11.61 (11.05-11.95) |
| CZA + MER | KP_Catania; KPC (16) | +3.04 (2.15-4.03) |


synergistic activity improved but did not overcome effects of high-inoculum infection
Specific Aim# 1: Establish the quantitative relationship in vitro between Tpos and carbapenamase-producing Enterobacterales (CPE) and define antibiotic concentration-effect relationships
Specific Aim#2: Pilot observational clinical study in 20 septic patients undergoing treatment for CPE to explore how early Tpos results with “indicator” isolates correlate with individual antibiotic PK/PD targets
Supervisors:
Funding:
Direzione Generale Della Ricerca Dell’ Innovazione in Sanità 2021-Bando Dell Ricerca

European Society of Clinical Microbiology and Infectious Diseases (ESCMID) 2022 Research Grants Program

Antibiotic powder:
